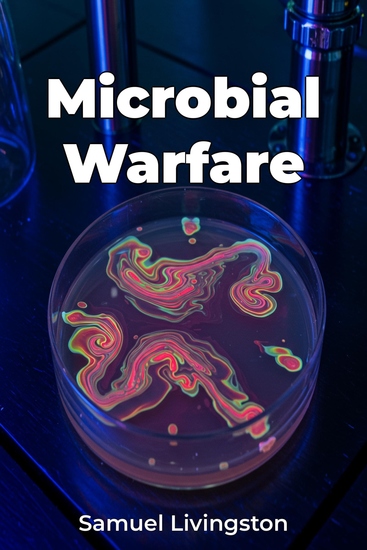

Microbial Warfare
Samuel Livingston
Traduttore A AI
Casa editrice: Publifye
Sinossi
Microbial Warfare explores the unsettling history of weaponized microbes, revealing how bacteria, viruses, and toxins have been manipulated as instruments of war and terror. This intersection of science, military history, and global security highlights the often-overlooked role of biological weapons in shaping conflict outcomes. From the ancient use of disease to weaken enemies to the 20th century's state-sponsored bioweapons programs, the book examines both historical incidents and the potential for future threats involving pathogens like anthrax, plague, and smallpox. The book uniquely integrates military history with microbiology and ethical considerations, providing a critical analysis of the forces driving bioweapon development. It not only details the science behind microbial virulence but also analyzes international treaties and laws designed to prohibit bioweapons. By tracing the evolution of bioweapons from ancient times through the post-9/11 era, the book offers a comprehensive understanding of bioterrorism and biodefense. Beginning with historical anecdotes, the book progresses through key periods, scrutinizing the science behind weaponized microbes and analyzing legal frameworks. This approach, supported by meticulously researched historical records and scientific publications, makes the book valuable for policymakers, public health officials, and anyone seeking a deeper understanding of this complex aspect of military strategy and global security.














